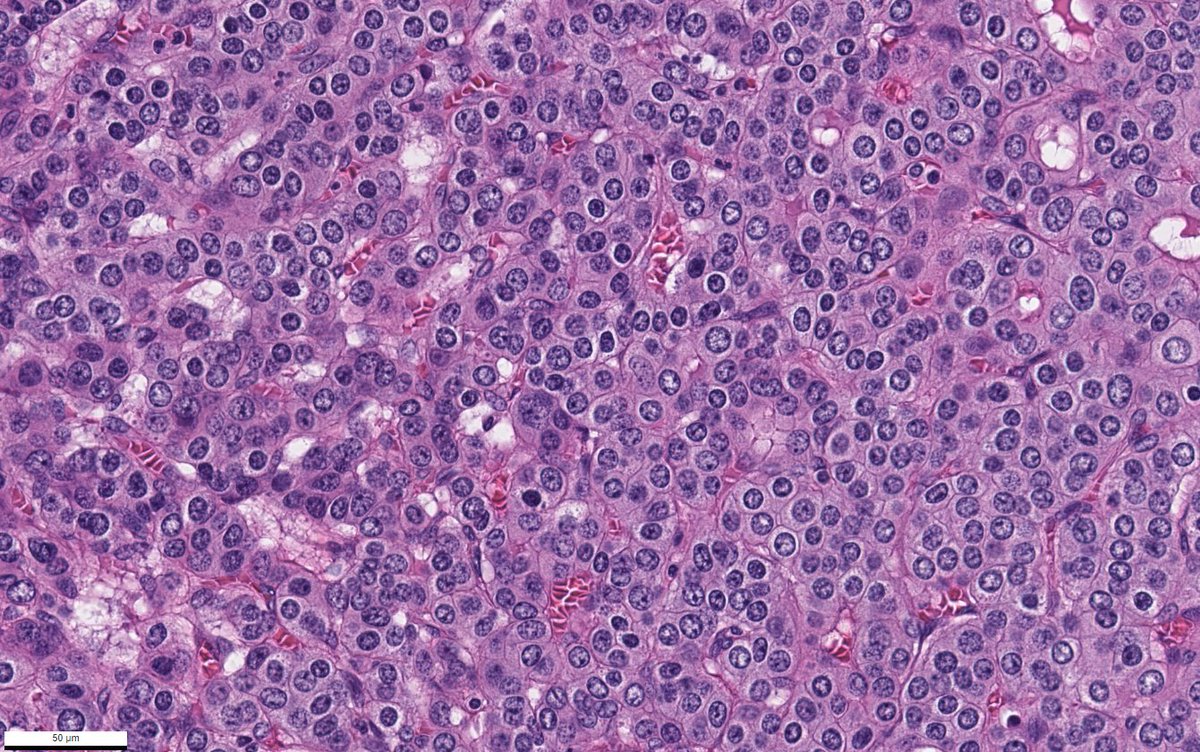
Vladimir Kushnarev tweet media
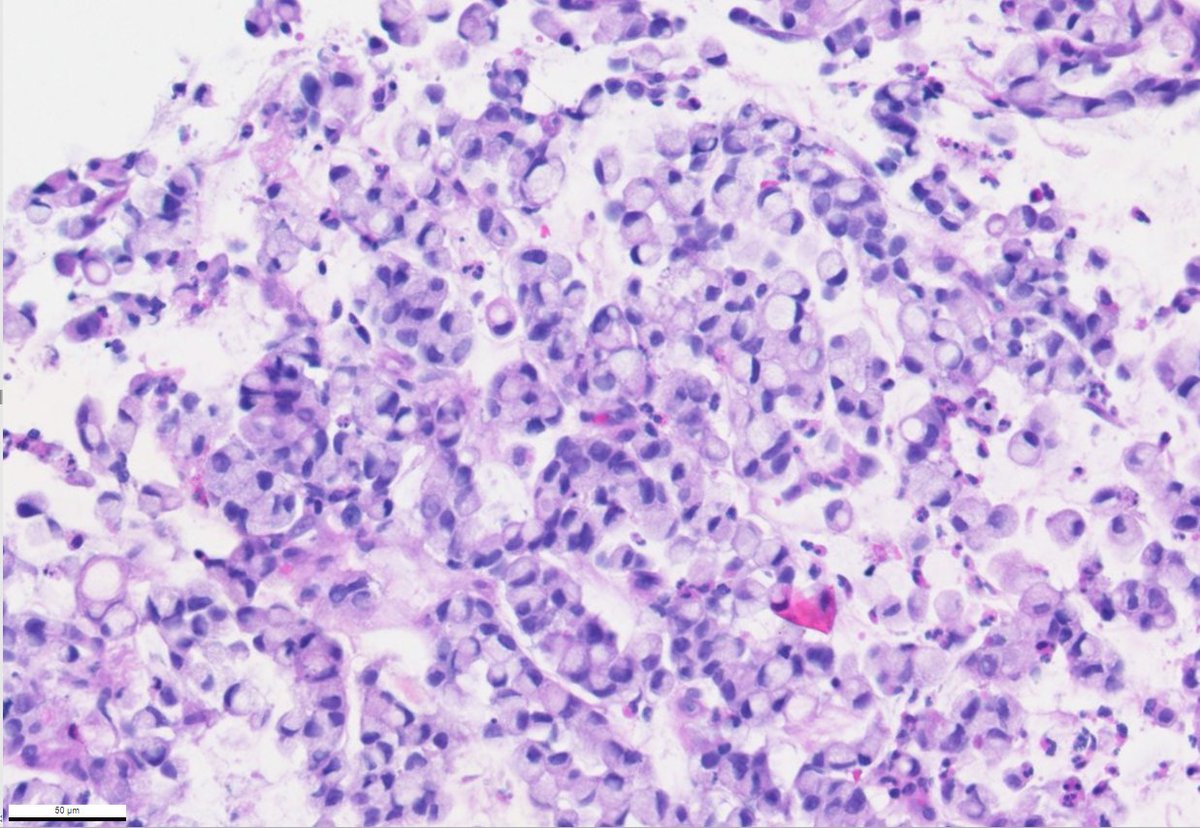
Vladimir Kushnarev tweet media

@deniswirtz I remember trying to create reconstructions using 3D Histech software in 2022. Have you tried making the first five slides (or, in theory, fewer) and then five at the end for reconstruction? I'd love to hear you and your presentation.
English